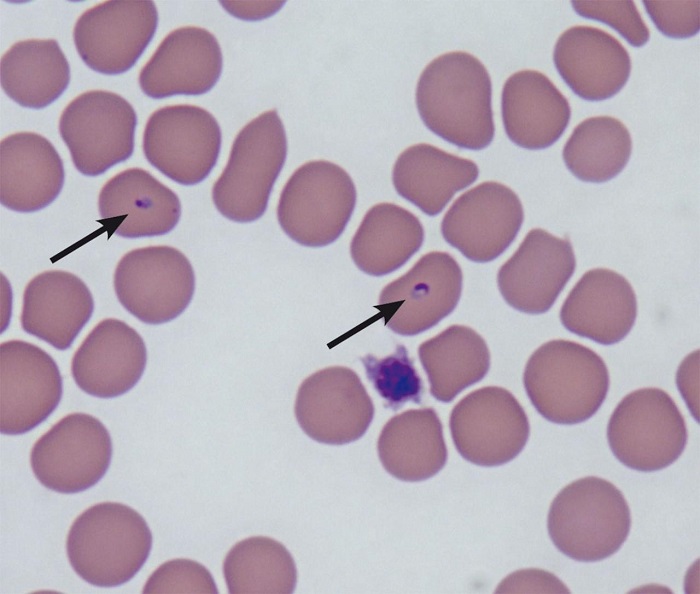
Мікоплазма під мікроскопом

Зміст статті
Мікоплазмоз у кішок – бактеріальне інфекційне захворювання, яке призводить до ураження очей, суглобів, дихальної, сечостатевої та інших систем. Головна небезпека інфекції полягає в тому, що через схожі симптоми її легко сплутати зі звичайною застудою або кон’юнктивітом. У зв’язку із цим власники кішок починають боротися з мікоплазмозом неправильно. У цей час бактерія посилено розмножується, завдаючи все більше шкоди організму та провокуючи ускладнення, при цьому кішка стає джерелом зараження для інших тварин. Саме тому важливо знати, який негативний ефект має мікоплазмоз на здоров’я вихованця та як захистити кішку від розвитку патології. Тільки вчасно надана допомога дозволить зупинити розвиток мікоплазмозу та запобігатиме небезпечним ускладненням.
Причини та шляхи зараження
Мікоплазми – це найпростіші, які не мають клітинної стінки, тому несприятливі умови призводять до їх швидкої загибелі. Мікроби мешкають усюди, господар кішки може занести їх на одязі чи взуттю до будинку. Однак заразитись мікоплазмозом кішка може лише шляхом прямого контакту з хворим родичем.
У хворої тварини збудник міститься у всіх біологічних рідинах: крові, слині, сльозах, спермі. У зв’язку з цим шляхи зараження мікоплазмозом різноманітні: через вилизування та покусування один одного, під час парування, через плаценту.
Основною причиною мікоплазмозу у кішок є ослаблений імунітет. Серед факторів, що провокують, можна відзначити:
- хронічне захворювання;
- вік – недостатньо сформована імунна система у новонароджених кошенят і виснажена у літніх кішок / котів;
- бідне / неякісне харчування;
- погані умови проживання.
До групи ризику входять кішки, які проживають скучено, наприклад, у притулку чи підвалі.
Симптоми мікоплазмозу у котів
Мікоплазми руйнують клітини організму господаря, виділяючи при цьому свої токсини. Якщо хвороба розвивається у гострій формі, перші симптоми інтоксикації виявляться приблизно через 10 днів після інфікування. До них відносяться:
- млявість, апатія;
- посилене виділення слізної рідини, слини;
- кон’юнктивіт;
- чхання;
- кашель;
- порушення випорожнень;
- лихоманка.
Ознаки гострої форми мікоплазмозу виражені яскраво. Звернення до ветеринарної клініки та своєчасне лікування призводять до швидкого одужання тварини. В іншому випадку хвороба набуває хронічного перебігу.
Хронічний мікоплазмоз протікає мляво, з чергуванням періодів затишшя та загострень. Симптоматика під час рецидивів нагадує невелику застуду: у кішки іноді з’являється нежить, запалюються очі, вихованець при цьому покашлює або чхає. У період ремісії кіт може бути активним, їсти. Однак у цей час відбувається поступове ушкодження внутрішніх органів, що може виявлятися такими симптомами:
- ураження суглобів, кульгавість;
- гнійні виділення із очей;
- збільшення лімфатичних вузлів;
- блідість слизової порожнини рота;
- потьмяніння та випадання шерсті;
- проблеми із сечовипусканням.
Трапляються і випадки носійства мікоплазми, коли збудник присутній в організмі кішки, вона може заразити інших родичів, але ознаки хвороби у неї відсутні.
Як проводять діагностику?
Самостійна діагностика мікоплазмозу у кішки неможлива, оскільки ознаки захворювання схожі на інші патології, наприклад, вірусні інфекції, хламідіоз. Домашнє лікування, засноване лише на симптомах, може сильно нашкодити вихованцю.
У клініці фахівець вислухає скарги, проведе огляд тварини, призначить аналізи крові, сечі. Збудника визначають за допомогою методу ПЛР або ІФА. У деяких випадках достатньо змиву, взятого з ока кішки або зі статевих органів.
Лікування мікоплазмозу у котів / кішок
При підтвердженому діагнозі ветеринар складає схему лікування. Основні завдання терапії: знищення збудника, усунення симптомів, підвищення імунітету. Правильно підібрані ліки покращують стан вихованця вже на 3-5 день.
До комплексу лікування мікоплазмозу може входити широкий ряд препаратів:
- антибіотики – таблетки чи порошки (Доксициклін, Гентаміцин);
- протимікробні та протизапальні краплі для очей та в ніс (Ципролет, Фоспрені);
- фізрозчин для промивання слизових оболонок;
- препарати для підтримання печінки (Гепатовет);
- пробіотики для відновлення мікрофлори кишечника (Зендакім);
- імуностимулюючі препарати (Гамапрен).
Тривалість лікування мікоплазмозу залежить від стану кішки, форми перебігу хвороби, супутніх симптомів та інших факторів. У середньому терапія триває 1-2 тижні. Якщо тварина перебуває у дуже тяжкому стані, її поміщають у стаціонар. В інших випадках достатньо домашнього лікування.
Як доглядати за вихованцем вдома?
Прискорити одужання допоможе уважне та дбайливе ставлення до кішки / кота. Від господаря вимагається:
- суворо дотримуватися дозування ліків та схеми лікування;
- не брати вихованця на руки, зайвий раз не турбувати, тому що у нього можуть блдіти суглоби;
- забезпечити йому м’яку підстилку;
- не випускати тварину надвір;
- обмежити переміщення кішки по квартирі;
- поставити миску з їжею та водою поряд з нею.
Якщо у будинку є інші тварини, кота потрібно тимчасово ізолювати.
Чи потрібна кішці дієта?
Якщо у вихованця при мікоплазмозі спостерігаються проблеми зі стільцем, потрібно дотримуватися лікувальної дієти. Напрямок та особливості залежатимуть від конкретних симптомів – діарея чи запор, нудота, відмова від їжі тощо. В інших випадках достатньо давати коту легкозасвоювану їжу кілька разів на день, але потроху. Можна перевести вихованця на спеціалізовані промислові корми, збільшивши при цьому обсяг питної води.
Можливі ускладнення мікоплазмозу
При занедбаному захворюванні, імунодефіциті, сильно ослабленому організмі внаслідок інших патологій у кішки навіть на фоні лікування можуть розвинутися ускладнення:
- патології суглобів;
- ураження печінки;
- пневмонія, набряк легень;
- виразки на шкірі, абсцеси;
- викидні у вагітних кішок;
- ниркова недостатність;
- запалення сечового міхура;
- простатит;
- гнійний кон’юнктивіт.
Якщо кішка захворіла на мікоплазмоз під час вагітності, то у неї можуть бути викидні або кошенята народяться мертвими. При народженні живих малюків надії на їхнє подальше існування мало – вони гинуть або від вроджених аномалій, або через занадто слабкий імунітет.
Чи можуть заразитися інші тварини чи людина?
Чи передається людині мікоплазмоз від кішки? Існує думка, що котячі штами мікоплазми не є небезпечними для людей і тварин інших видів. Але це не означає, що потрібно нехтувати правилами безпеки та перевіряти це на практиці. Захворілого кота потрібно ізолювати від інших вихованців, а під час догляду за ним дотримуватися запобіжних заходів:
- не цілувати;
- проводити антисептичну обробку миски та підстилки;
- не дозволяти іншим тваринам пити і їсти з миски кішки, яка захворіла;
- стежити за гігієною рук.
Особливо це стосується дітей, людей похилого віку та осіб, які страждають на тяжкі хронічні хвороби, з імунодефіцитами, після оперативного втручання.
Профілактика мікоплазмозу у кішок
Вакцинація кішок від мікоплазмозу не проводиться. Профілактика полягає в тому, щоб зміцнювати імунну систему тварини всіма можливими способами:
- забезпечити повноцінне харчування;
- своєчасно звертатися до ветеринару;
- в’язати кішку лише з перевіреним партнером;
- не допускати контактів із вуличними котами;
- не пропускати планову вакцинацію;
- містити / утримувати у чистоті предмети, призначені для вусатого друга.
Не слід забувати про періодичні профогляди в клініці. Достатньо один раз на рік здавати аналізи крові та сечі, щоб попередити, виявити чи вилікувати багато прихованих та небезпечних хвороб.
Тема 2026: комфорт і турбота про улюбленців.












⚠️ Усі висновки на нашому порталі ми пропонуємо вам прочитати і взяти до відома на ваш розсуд. Не займайтеся самолікуванням! У наших статтях ми збираємо останні наукові дані та думки авторитетних експертів у галузі здоров'я. Але пам'ятайте: поставити діагноз та призначити лікування може лише лікар.
Портал призначений для користувачів старше 13 років. Деякі матеріали можуть не підходити для дітей молодше 16 років. Ми не збираємо персональні дані у дітей молодше 13 років без згоди батьків.У нас є невелике прохання. Ми намагаємося створювати якісний контент, який допомагає піклуватися про домашніх вихованців, і робимо його доступним безоплатно для всіх, тому що віримо, що кожен заслуговує на точну і корисну інформацію.
Рекламні доходи покривають лише невелику частину наших витрат, і ми хочемо продовжувати надавати контент без необхідності збільшувати кількість реклами. Якщо наші матеріали виявилися вам корисними, будь ласка, підтримайте нас. Це займе всього хвилину, але ваша підтримка допоможе нам скоротити залежність від реклами і створювати ще більше корисних статей. Дякуємо!


